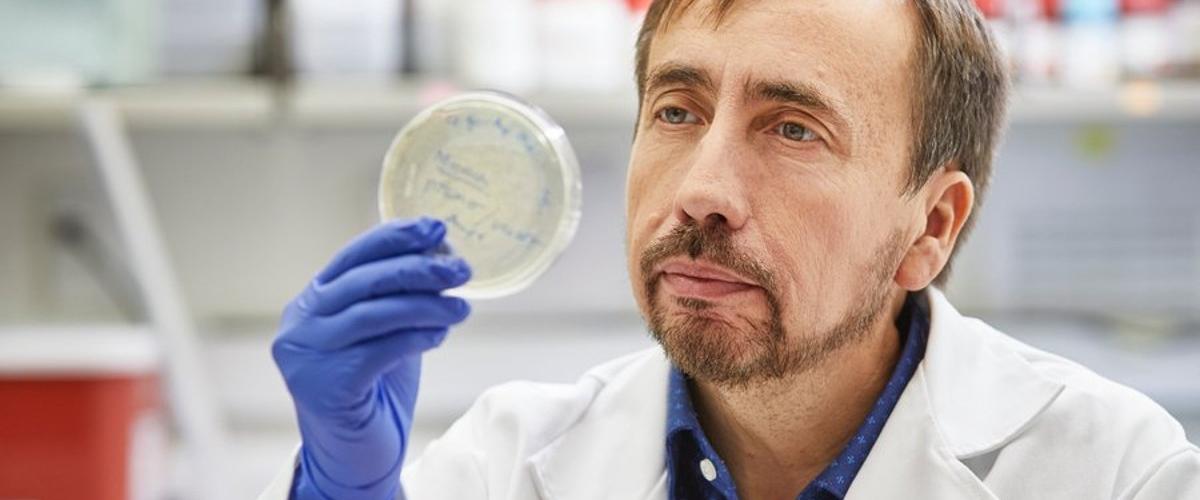
TODO:

Агрегации бета-амилоидных и тау белков в головном мозге считаются основным признаком развития нейродегенерации. Между тем сложности преодоления защитного гематоэнцефалического барьера мозга затрудняют доставку препаратов для их удаления. Из предыдущих исследований команда из Техасского университета знала, что манипуляции с циркулирующими компонентами крови могут быть перспективной терапевтической мишенью.
Новая работа показала, что основанная на переливании крови стратегия действительно обладает потенциалом для простого лечения болезни Альцгеймера — наиболее распространенной формы деменции.
Эксперименты на моделях мышей с болезнью Альцгеймера продемонстрировали: переливания крови снизили уровень амилоидных бляшек на 40-80%. Это снижение улучшило память грызунов и сократило рост новых агрегаций в дальнейшем.
Главным преимуществом нового подхода является простота, считают авторы. Результаты показывают, что с неизлечимой болезнью можно справиться через кровеносную систему, а не через воздействие на мозг.
Между тем пока не ясно, как переливание крови воздействует на агрегацию амилоидов. Сейчас авторы изучают несколько гипотез, однако очевидно, что независимо от механизма процедуры по «очищению» крови могут стать новым методом лечения болезни Альцгеймера у людей в будущем.
Ранее ученые обнаружили, что важной стратегией профилактики деменции может стать регулярное посещение стоматолога. Их работа показала, что болезни десен ускоряют процесс нейродегенерации.